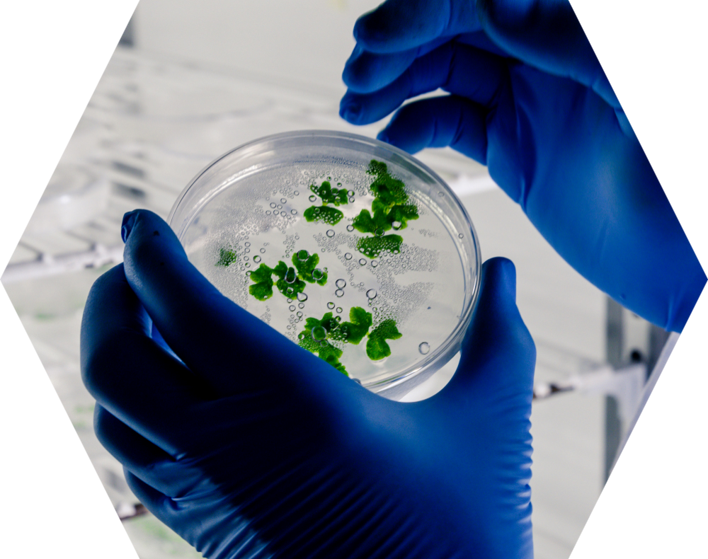

Our Divisions
GreentriX BioTree
Smart Urban Solutions
GreentriX Biomass
Waste to Energy
BioLumut GrowOps
Algae Cultivation for Bio-Crude
BioLumut Energy
Biofuel & Renewable
Power Generation
BioLumut Energy
Biofuel & Renewable Power Generation
GreentriX Research & Development
Innovation for Sustainable Future
GreentriX Foundation
Smart Green School Transformation